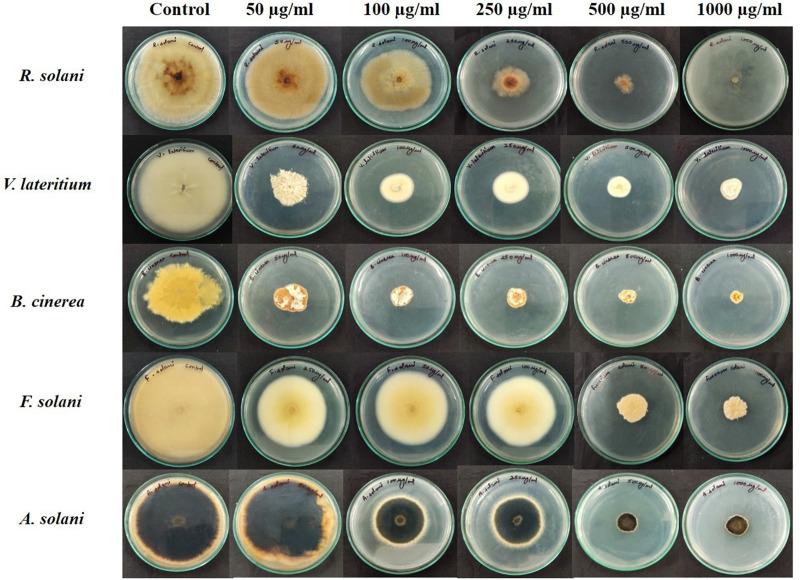
https://cdn.ncbi.nlm.nih.gov/pmc/blobs/985e/8222588/a384205603eb/fmicb-12-609482-g006.jpg

番茄种子细菌内生菌抗真菌活性筛选揭示产脂肽菌株NKIT9为潜在生物防治剂
Screening of Tomato Seed Bacterial Endophytes for Antifungal Activity Reveals Lipopeptide Producing Strain NKIT9 as a Potential Bio-Control Agent.
作者信息
Sharma Ayushi, Kaushik Nutan, Sharma Abhishek, Bajaj Abhay, Rasane Mandar, Shouche Yogesh S, Marzouk Takwa, Djébali Naceur
机构信息
Amity Food and Agriculture Foundation, Amity University Uttar Pradesh, Noida, India.
Amity Institute of Microbial Technology, Amity University Uttar Pradesh, Noida, India.
出版信息
Front Microbiol. 2021 Jun 10;12:609482. doi: 10.3389/fmicb.2021.609482. eCollection 2021.
The current study investigates the diversity pattern and fungicidal potential of bacterial endophytes isolated from two different organic varieties of tomato plants (V1 and V2). A total of seventy-five bacterial isolates identified by 16S rRNA gene sequencing revealed a majority of genus as and one , which were grouped into eight different species. The Shannon diversity H' (1.56), Simpson's index of diversity (0.93), Magalef' index (2.23), Evenness (0.96), and Species richness (7) indicated the high endophytic bacterial diversity in the V1 variety of the tomato. Bacterial endophytes isolated from both of the varieties were screened for their antifungal activity against five economically critical fungal pathogens (viz., , , , , and ) of tomato crop through dual culture assay. The data revealed strain NKIT9 as the most potent antagonist, significantly ( < 0.05) inhibiting the mycelial growth between 75 to 90% against selected fungal pathogens. High bioactivity of lipopeptide extract of strain NKIT9 was recorded against with minimum IC value of 230 μg/ml. The Ultra Performance Liquid Chromatography-High Definition Mass Spectrometry (UPLC-HDMS) analysis of this lipopeptide extract revealed the presence of Surfactin and Bacillomycin D. Furthermore, results showed that the selected bacterial strain significantly minimized the disease incidence in damping-off assay which makes this strain a promising antifungal bio-control agent. Moreover, in the pot experiment the NKIT9 increased the fruit yield by 59.2% compared with the untreated infested control.
本研究调查了从两种不同有机品种番茄植株(V1和V2)中分离出的细菌内生菌的多样性模式和杀真菌潜力。通过16S rRNA基因测序鉴定的75株细菌分离物显示,大多数属为 和一个 ,它们被分为8个不同的物种。香农多样性指数H'(1.56)、辛普森多样性指数(0.93)、马加莱夫指数(2.23)、均匀度(0.96)和物种丰富度(7)表明番茄V1品种中内生细菌多样性较高。通过双培养试验,对从这两个品种中分离出的细菌内生菌针对番茄作物的五种经济上至关重要的真菌病原体(即 、 、 、 和 )的抗真菌活性进行了筛选。数据显示菌株NKIT9是最有效的拮抗剂,对选定的真菌病原体的菌丝体生长有显著抑制作用( < 0.05),抑制率在75%至90%之间。记录到菌株NKIT9的脂肽提取物对 具有高生物活性,最低IC值为230 μg/ml。对该脂肽提取物的超高效液相色谱-高分辨质谱(UPLC-HDMS)分析显示存在表面活性素和芽孢霉素D。此外, 结果表明,所选细菌菌株在猝倒试验中显著降低了发病率,这使得该菌株成为一种有前景的抗真菌生物防治剂。此外,在盆栽试验中,与未处理的 侵染对照相比,NKIT9使果实产量提高了59.2%。